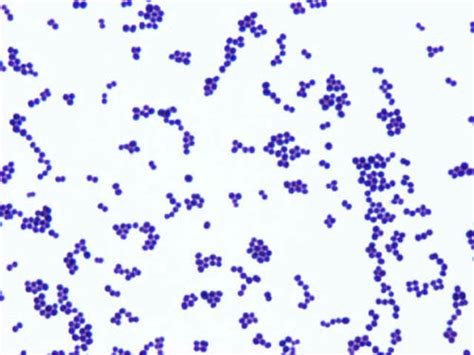

Infectious Disease Fellows Network
@id_fellows
Collaborative resource to promote ID clinical reasoning for #IDfellows | #IDTwitter #IDMedEd | idfellows.org | [email protected]
ID: 1285217588067401730
20-07-2020 14:18:54
1,1K Tweet
9,9K Followers
135 Following


Spring is officially here- and with it comes another round of the fellows cup! To get ready we need your help #IDTwitter! We're looking for both question writers and mentors - sign up here forms.gle/Fvykz7HsMuVspN… Infectious Disease Fellows Network Febrile IDSA Medical Education Community of Practice TxID Early Career Network


Are you a fellow trying to write a personal statement? Or a faculty member trying to guide your trainees? Infectious Disease Fellows Network Check out this article on writing personal statements in JGME by Dr. Jones, @ricapitt, & Kimberly D. Manning, MD, MACP pubmed.ncbi.nlm.nih.gov/36274771/ #IDMedEd #MedEd

Working on question topics for the 60 questions upcoming in the spring game! #IDTwitter Infectious Disease Fellows Network IDSA Medical Education Community of Practice What are some important topics to cover? For former players, any that should be revisited? Reply or DM suggestions you have!



Are you a fellow trying to write a personal statement? Or a faculty member trying to guide your trainees? Infectious Disease Fellows Network Check out this article on writing personal statements in JGME by Dr. Jones, @ricapitt, & Kimberly D. Manning, MD, MACP pubmed.ncbi.nlm.nih.gov/36274771/ #IDMedEd #MedEd

Rabindra Ghimire, MBBS, MD, FACP, FIDSA Carlos del Rio Brad Spellberg Saira Butt Shmuel Shoham David van Duin Taesung Kwon Priya Nori MD, FSHEA, FIDSA Excellent question from Dr. Ghimire. ID fellows and attendings, how is the situation are your center? ID fellows see max how many new consults per day? TxID Early Career Network Indiana University Infectious Diseases Fellowship University of Maryland ID Fellowship Program Infectious Disease Fellows Network BCM ID Fellowship Darcy Wooten she/her @DocWoc71 Josh Nosanchuk


Febrile lanyards will be on sale for the next 2 wks (just $5!), while they last. After this sale, you'll only be able to get them at special occasions/conferences where I can attend! Great gift for new ID fellows! Or a place to show off your IDFellowsCup pin :) #IDTwitter


📢Our Fall Game Sign-ups are live today!! Over 700 joined us in May from #IDMedEd, #IDtwitter community! Come join us again, this time to learn about impactful trials in ID! Sign-up link: redcap.link/FallCup2023 IDSA Medical Education Community of Practice, Infectious Disease Fellows Network Febrile 1/




Want to enhance your skills in digital medical education and social media? The ID Digital Institute (IDDI) is taking applications for our next class! More info: febrilepodcast.com/iddi/ App open thru Dec 19th!!: forms.gle/EA5JT3tN5NDq3G… #IDTwitter #IDMedEd Infectious Disease Fellows Network



Most patients with sepsis don't need anti-anaerobic antibiotics. But most get them anyway. Why not, what's the harm? I worry the harm is considerable. Our new study in JAMA Internal Medicine: using a 15-month pip-tazo shortage to answer this question. 1/n jamanetwork.com/journals/jamai…




Okay 𝒌𝒆𝒗𝒊𝒏 𝒌𝒆𝒍𝒍𝒆𝒓, you asked for a combo Abx therapy rant, so here it comes (I guess Im taking requests now! ;)). There are 3 philosophical reasons to use combination Abx therapy (see my Mandell chapter for this discussion in detail). But they all apply differently to difft dzs.